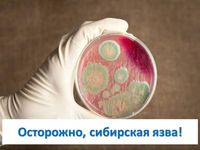

Сибирская язва
В России ежегодно регистрируются вспышки болезни сибирской язвы среди животных, приводящие к инфицированию людей. Наш регион не исключение.
Источник инфекции сибирской язвы является домашний скот и дикие животные. Домашняя птица к инфекции нечувствительна. Заражение человека происходит через прямой или косвенный контакт с больным животным. Восприимчивость людей к болезни зависит от механизма заражения и количества микробов, проникших в организм. Наиболее частый путь заражения контактный (при разделке туш, уходе за больными животными, контакте с мясом, шерстью и меховыми изделиями, когда споры или вегетативные формы попадают на травмированную кожу или слизистые оболочки), затем воздушно – пылевой путь (при вдыхании загрязнённой костной муки и пыли). Не нужно забывать о возможности передачи заболевания через инфицированные продукты, сырье, предметы, содержащие бактерии возбудителя.
В большинстве случаев болезнь поражает кожные покровы, эта форма заболевания у людей — карбункулезная. Первые проявления возникают через 2-3 суток. Поднимается температура, на открытых участках кожи сначала появляются пятна, похожие на укус насекомого, а через сутки на месте поражения появляется пузырек – карбункул с кровянистой жидкостью.
Профилактические мероприятия направлены на контроль над распространением инфекции. А это в первую очередь выявление больных животных, соблюдение ветеринарных и санитарных норм, вакцинация от сибирской язвы домашнего скота и людей.
Материал подготовлен к публикации отделом подготовки и тиражирования информационных медицинских материалов ГБУЗ «ВРЦОЗ И МП» под редакцией Мельниковой Л.Б.